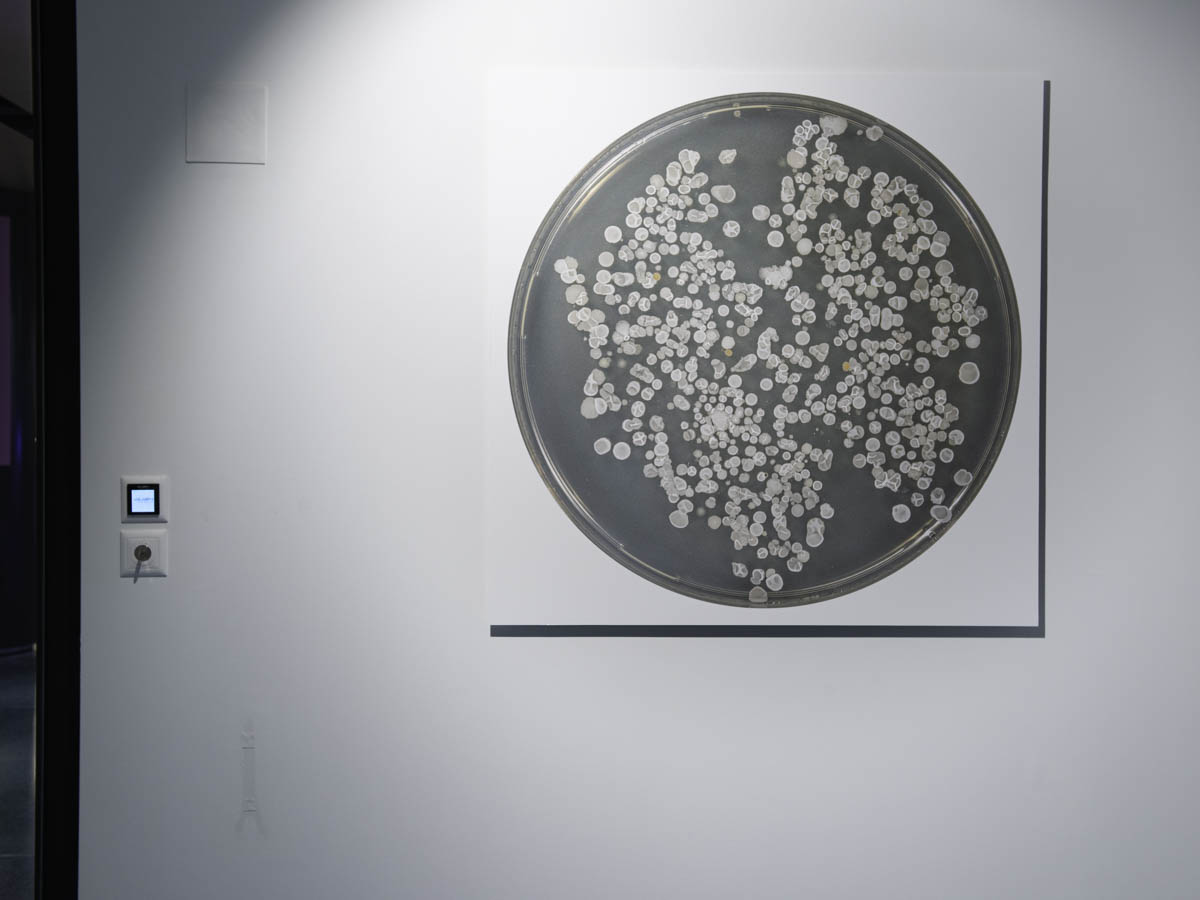

ARTICULATIONS, Standard/Deluxe, Lausanne, 2025
Exposition en cocréation avec Florence Vuilleumier | exposition, lectures et diaporama autour des livres Droit au vertige & Entredeux aux éditions art&fiction.










Exposition en cocréation avec Florence Vuilleumier | exposition, lectures et diaporama autour des livres Droit au vertige & Entredeux aux éditions art&fiction.









Exposition en cocréation avec Florence Vuilleumier, avec le soutien de pro Helvetia Shanghai – The Swiss Arts Council 由瑞士文化基金会上海办公室支持.

Exposition en co-création avec Florence Vuilleumier | exposition à Genève Confédération Centre.